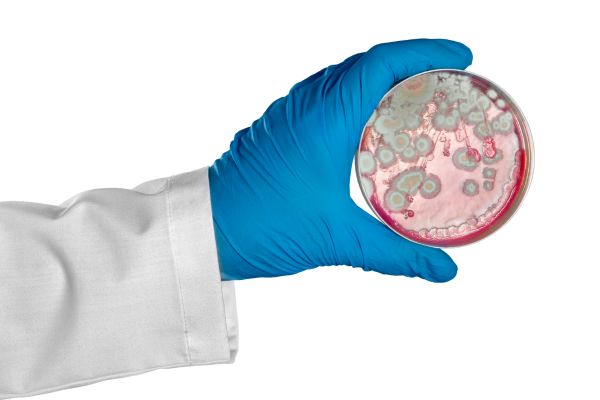
Penészesedik a fal - egészségtelen

Manapság egyre gyakoribb és zavaró az a probléma, ha penészesedik a fal. Vannak jó és kevésbé jó trükkök, praktikák ennek megelőzésére és eltüntetésére. A következő sorokban ezeket fogjuk megnézni.
Az előző cikkben szó esett a kőzet- és üveggyapot tulajdonságairól is, és miért is jó.
Tippek, ha penészesedik a fal
Ha penészesedik a fal, a megfelelő szellőztetéssel és páramentesítéssel csökkenthető a levegő nedvességtartalma, ami hozzájárul a penész képződésének megelőzéséhez.
Szakszerű szigetelés: Bizonyos esetekben a helytelenül szigetelt falak okozzák a penészképződést. A megfelelő szigetelés javítása segíthet csökkenteni a nedvesség és penész kialakulását.
Penészálló festékek és bevonatok: Speciális penészálló festékek és bevonatok használata segíthet a penész elleni védekezésben és a már kialakult penész eltávolításában.
Nedvességforrások megszüntetése: Ha penész képződik, először az okokat kell megszüntetni. Például szivárgó csövek vagy szivárgások okozta nedvesség forrásait célszerű kiküszöbölni.
Ecet vagy hidrogén-peroxid használata: Könnyebb penészfoltok esetén ecet vagy híg hidrogén-peroxid oldattal lehet tisztítani. Ebben az esetben fontos a megfelelő szellőztetés és védőfelszerelés használata!
Szakember bevonása: Súlyosabb penészproblémák esetén érdemes szakember segítségét kérni. Az ő szaktudásukkal hatékonyabban lehet kezelni a problémát, és megoldást találni a penész elleni védekezésre.
A penészesedés egészségügyi háttere
A penész sajnos komoly egészségügyi problémákat is hordoz magával.
A penészgombák a levegőben apró, láthatatlan spórákat bocsátanak ki, ezzel egészségügyi problémát okozva a helységben hosszabb ideig tartózkodóknak. Allergiás reakciókat, asztmás tüneteket, légúti irritációt és más egészségügyi problémákat okozhatnak, különösen az érzékeny emberek esetében.
A penészgombák által kibocsátott anyagok a belélegzett levegővel könnyen bejuthat a tüdőbe, ami légzési nehézségeket és légszomjat is okozhat. A penész okozta spórák allergiás reakciókat válthatnak ki, mint például orrfolyást vagy tüsszögést.
Bizonyos penészgombák mérgező anyagokat termelhetnek, mint a penészölő vegyszerekhez hasonlókat. Ezek az anyagok egészségkárosító hatásokat eredményezhetnek. Emiatt is, ha magunk oldjuk meg a penész problémát vegyszerekkel, ne tartózkodjunk sokáig a szobában, illetve a helyiséget szellőztessük, hogy a vegyszer minél hamarabb távozhasson a lakásból.
Azonban a penész hosszútávú hatásai nem csak az egészségre, hanem az épület szerkezetére is kihatnak. A nedvesség a falak szerkezetében okozhat sérüléseket, amik a penészképződés terjedésével egyre súlyosabbá válhatnak.
A penésszel teli falak az életminőséget is negatívan befolyásolják. A kellemetlen szagok és a penész látványa miatt a lakhatási környezet zavaró és elviselhetetlen lesz.

Mi okozhatja a penészesedést?
A leggyakoribb ok a magas páratartalom. Ha a lakás levegője túl nedves, akkor a nedvesség könnyen lerakódik a falak felületén, ami ideális környezetet teremt a penésznek.
Rossz szellőzés: Nem megfelelő szellőzés vagy rosszul működő szellőzőrendszer miatt, a nedvesség a lakásban marad és penészképződéshez vezethet.
Szivárgások: Szivárgások a falakon vagy tetőn is okozhatnak ilyen problémát, mivel állandóan nedvesség éri a felületeket.
Helytelen szigetelés: A rosszul szigetelt falak hőhidakat hoznak létre, ahol a meleg és hideg levegő találkozik. Ez pedig penészképződést okozhat.
Rosszul szigetelt vízvezetékek: Rosszul szigetelt vagy szivárgó vízvezetékek is okozhatnak nedvességfelhalmozódást a falakban.
Rosszul szigetelt ablakok és ajtók: Az alacsony minőségű vagy rosszul szigetelt ablakok és ajtók is hozzájárulhatnak a penészképződéshez.
Elhanyagolt páramentesítés: Ha nincs megfelelő páramentesítő rendszer a lakásban, akkor a nedvesség szintén felhalmozódhat.
A penész nem csak esztétikailag problémás, hanem egészségügyi problémákat is okozhat. Fontos tehát a megelőzés és a probléma időbeni kezelése.
Penész és az évszakok

A penészképződés általában nedves és meleg környezetben alakul ki, így általában tavasszal és ősszel fordul elő. Ezek az évszakok a nedvességtől és változékony hőmérséklettől való fokozottabb kitettség miatt kedvező időszakok a penészgombák szaporodására és terjedésére.
Tavasszal az esőzések, hóolvadás és a magas páratartalom miatt a falak nedvesek lehetnek, és a melegedő időjárás lehetővé teszi a penészgombák szaporodását. Ősszel pedig az esőzések és az alacsonyabb hőmérséklet miatt is hasonló helyzet alakulhat ki.
A fűtésiszezon alatt, a lakásokban használt fűtőberendezések és radiátorok megnövelhetik a benti levegő szárazságát, mivel a fűtési rendszerek hajlamosak kiszárítani a levegőt. Emiatt a penészgombák nehezebben szaporodnak és terjednek.
Fontos azonban megjegyezni, hogy a penészgombák bármikor megjelenhetnek, ha a környezet nedves és meleg. Az épület nedvességtartalma, szellőzése és hőmérséklete is befolyásolja a penészképződést, így fontos ezeket az elemeket figyelemmel kísérni és kezelni a penész elkerülése érdekében.
Összegezve, ha a leírtak alapján megfigyeljük, mikor és hol keletkezhet a probléma forrása, könnyen megállíthatjuk a penész kialakulását és annak elhatalmasodását otthonunkban. Ha ezzel a nehézséggel vagy bármi mással kapcsolatban kérdése van felénk, keresse bizalommal a Buda-Házépítő Kft-t, és mi segítünk megoldani minden felmerülő kérdését!